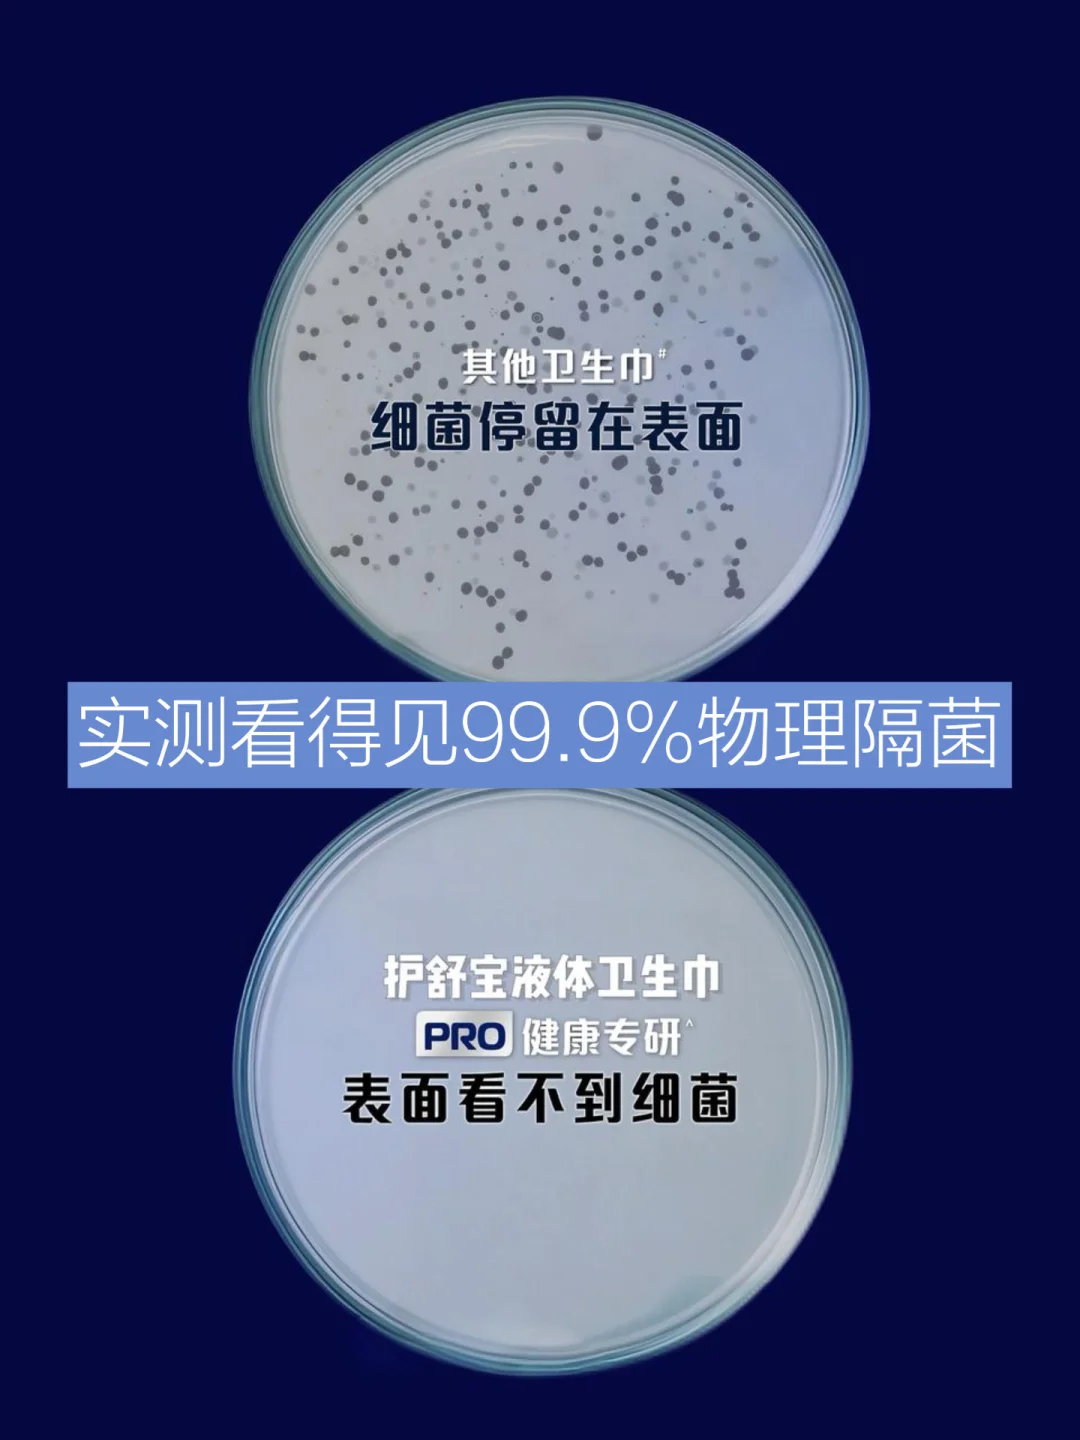

经期这几天 就想吃点热呼呼的食物
一碗三文鱼菌菇烩饭🥣
唤醒身体的能量,吃完暖乎乎很舒服~
煎得焦脆的三文鱼🍣;外tree里嫩,完全没有腥味
浓稠的酱汁裹满了每一粒米
一口下去糯叽叽超糊嘴~
吃起来是淡淡的奶香还混合着菌菇的鲜香
太好吃了😋
除了好好吃饭摄取足够的能量外
经期的防护也尤为重要,特别像我这种高敏肌人群
一到秋天不是这里红就是那里痒
更别说经期湿漉漉的时候了……简直是痒到不行!!
所以我现在挑卫生巾不仅仅是看舒适度
更重要的是适合咱这敏肌!
这款护舒宝新品物理隔菌卫生巾
就是我大浪淘沙下淘出的“金品”!!
用了一回你就会爱上!
不像普通卫生巾一样,它是用了一个很牛的技术
独创的单向导湿表层
经血一接触到卫生巾表层就被迅速吸收!
就像在肌肤和细菌的中间搭了一个“物理防护盾”
隔绝99.9%的经血细菌
表面干爽,完全没有黏在皮肤上的感觉
我这高敏肌用着也太香了
开会久坐一下午肌肤还是清清爽爽的
私处一点都没有闷痒粘腻的感觉
而且还是婴儿级类肤表层
软乎乎的材质像是被柔软的云朵包裹
舒适度拉满!
这样来月经的时候做饭,也可以清清爽爽
无痕无感一整天啦~
双11大促快来啦!现在买第二套直接0元
15号晚8点开抢,定好闹钟⏰抓紧冲起来!
End希望大家也都能在经期舒心度过!